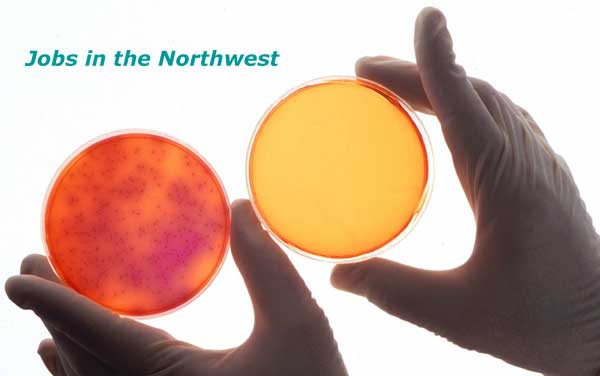

Creating
opportunities in life sciences communications
Home
Resume Help
Networking Tips
Resource Links
Jobs >>
Newsletter
About
|
|
|
|
|
|
|
|
|
|
|
|
|
|
The information
listed here is subject to
change.
We will be updating this page
frequently, so do check back with us soon!
Last Update: January
22, 2006 |
|
|
|
|
|
|
|
| Employer |
Position |
Contact Person |
Company Phone |
|
|
|
|
| ICOS Corporation |
Associate Director |
Karen Fenstermacher |
425-485-1900 |
| Corus Pharma, Inc. |
Sr Mgr, Clin Microbiologist |
careers@coruspharma.com |
206-728-5090 |
| MDS Pharma Services |
Scientist, MALDI Imaging |
Careers Page |
425-487-8200 |
| MDS Pharma Services |
Dir, Pharma Data Systems |
Careers Page |
425-487-8200 |
| ZymoGenetics, Inc. |
Senior Biostatistician |
zymo@rpc.webhire.com |
206-442-6600 |
| Ikaria, Inc. |
Director/Sr Director |
hr@ikariainc.com |
206-957-7373 |
| Northstar Neuroscience |
Software Quality Engr |
jobs@northstarneuro.com |
800-896-4312 |
| Corus Pharma, Inc. |
Sr SAS Programmer |
careers@coruspharma.com |
206-728-5090 |
| Fred Hutchinson Cancer
Res Ctr |
Clinical Research Monitor |
Careers Page |
206-667-4700 |
| Seattle Genetics, Inc. |
Head, Translational Biol |
hr@seagen.com |
425-527-4000 |
| Seattle Genetics, Inc. |
Medical Oncologist |
hr@seagen.com |
425-527-4000 |
| 2005 Philips |
Proposal Developer |
Philips Recruiting |
425-487-7000 |
| ICOS Corporation |
Scientific Writer 2280 |
Karen Fenstermacher |
425-485-1900 |
| Bradson Technology |
Technical Writer |
Michael Whalen |
425-456-8900 |
| ID Biomedical Inc. |
Reg Affairs Mgr/Dir |
Human Resources |
425-482-2502 |
| Meridian Group |
Investor Relations |
HR Department |
206-621-9301 |
| Onyx Software |
IR Director |
Kevin Coneferey (VP, HR) |
425-451-8060 |
| WA State
Pharm. Assoc. |
MarCom Mgr |
B. Stark |
|
| KJM and Assoc |
MarCom Specialist |
Michelle Bauers
(VP, HR) |
425-451-3881 |
| Zymogenetics |
Med Writer - Pubs |
|
206-442-6600 |
| Zymogenetics |
Reg Affairs, E-Subs |
|
206-442-6600 |
| Medtronic |
Clinical Study Mgr |
Janet Fiola (VP,
HR) |
425-867-4000 |
| Providence Health Sys |
Communications |
|
206-464-3355 |
| Medwebs Web Design |
Medical Web Designer |
General Contact |
+44-1329-280-975 |
|
|
|
|
|
VoxMedicus offers additional services such as resume help and a free
newsletter. You can contact us or learn more
about us. >>
|
|